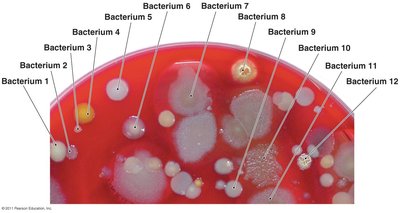
Bacterial colonies on agar

BackIntroduction to Medical Microbiology: History, Classification, and Key Discoveries
Study Guide - Smart Notes
Tailored notes based on your materials, expanded with key definitions, examples, and context.
Medical Microbiology: An Introduction
Overview of Microorganisms
Microorganisms (m.o.) are ubiquitous and play essential roles in various ecosystems. They are involved in processes such as nitrogen fixation for plants, digestion in animals, waste degradation in ecosystems, and the production of foods, vaccines, and antibiotics. While many microorganisms are beneficial, some can be harmful and cause disease.
Plants require microorganisms for nitrogen acquisition.
Animals depend on microorganisms for digestion.
Ecosystems rely on microorganisms for waste degradation.
Industrial uses include the production of wine, cheese, vaccines, and antibiotics.
The Early Years of Microbiology
Antoni van Leeuwenhoek and the Discovery of Microorganisms
Antoni van Leeuwenhoek, a Dutch merchant, was the first to observe and describe microorganisms using simple microscopes he constructed himself. His observations included tiny animals, fungi, algae, and protozoa, which he called "animalcules." By the late 19th century, these organisms were collectively known as microorganisms.

Leeuwenhoek reported protozoa in 1674 and bacteria in 1676.
He used simple microscopes with a single convex lens and a specimen holder.

The Microbial World
Leeuwenhoek's discoveries revealed a previously unseen world of microscopic life, including bacteria, protozoa, and algae.

Classification of Microorganisms
Carolus Linnaeus developed a taxonomic system for naming and classifying organisms. Leeuwenhoek’s microorganisms were grouped into six categories:
Fungi (eukaryotic)
Protozoa
Algae
Bacteria
Archaea
Small multicellular animals
Fungi
Fungi are eukaryotic organisms that obtain food from other organisms and possess cell walls. They exist in various forms:
Molds: Multicellular, grow as long filaments (hyphae), reproduce by sexual and asexual spores.
Yeasts: Unicellular, reproduce asexually by budding, some produce sexual spores.

Protozoa
Protozoa are single-celled eukaryotes similar to animals in their nutritional needs and cellular structure. Most live freely in water, some in animal hosts, and reproduce asexually or sexually. They are classified by their locomotion:
Pseudopodia: Cell extensions that flow in the direction of travel.
Cilia: Numerous, short protrusions that propel the organism.
Flagella: Fewer, longer, and more whiplike than cilia.

Algae
Algae are photosynthetic organisms that can be unicellular or multicellular. They are categorized based on pigmentation, storage products, and cell wall composition.

Bacteria and Archaea
Bacteria and archaea are unicellular organisms lacking nuclei (prokaryotes). They are smaller than eukaryotes and reproduce asexually. Bacteria have cell walls containing peptidoglycan, while archaea have cell walls made of other polymers.

Other Microorganisms
Parasitic worms: Range from microscopic to several meters in length.
Viruses: Acellular entities that infect bacteria, plants, and animals.

The Golden Age of Microbiology
Spontaneous Generation Debate
After Leeuwenhoek, the study of microbiology slowed due to limited access to microscopes. The theory of spontaneous generation (abiogenesis) posited that life could arise from nonliving matter. This idea was debated for centuries.
Key Experiments Disproving Spontaneous Generation
Redi’s Experiments (1668): Showed that maggots only appeared in meat exposed to flies, challenging spontaneous generation.

Needham’s Experiments (1749): Supported spontaneous generation but had methodological flaws.
Spallanzani’s Experiments (1729-1799): Demonstrated that boiled and sealed broth did not produce life, suggesting contamination from air.
Pasteur’s Experiments (late 1800s): Used swan-necked flasks to show that microorganisms in the air, not spontaneous generation, caused microbial growth.

The Scientific Method
The debate over spontaneous generation contributed to the development of the scientific method, a systematic approach to scientific inquiry.
Observation leads to a question.
A hypothesis is formulated and tested through experiments.
Results are used to accept, reject, or modify the hypothesis, leading to theories or laws.

Fermentation and Industrial Microbiology
Fermentation research in the 19th century led to the field of industrial microbiology. Pasteur and Buchner demonstrated that living organisms and enzymes, respectively, are responsible for fermentation, not just air or spontaneous processes.

Pasteurization: Heating liquids to kill microorganisms and prevent spoilage.
Buchner’s discovery of enzymes initiated the field of biochemistry and metabolism studies.
Industrial Uses of Microbes
Product or Process | Contribution of Microorganism |
|---|---|
Cheese | Flavoring and ripening by bacteria and fungi |
Alcoholic beverages | Alcohol production by bacteria or yeast |
Soy sauce | Fungal fermentation of soybeans |
Vinegar | Bacterial fermentation of sugar |
Yogurt | Bacteria growing in milk |
Sour cream | Bacteria growing in cream |
Artificial sweetener | Amino acids synthesized by bacteria |
Bread | Yeast fermentation produces CO2 for dough rising |

The Germ Theory of Disease
Pasteur proposed that microorganisms cause disease (germ theory). Robert Koch further developed this idea by identifying specific pathogens responsible for diseases such as anthrax and tuberculosis.

Koch developed techniques such as simple staining, photomicrography, and the use of Petri dishes.
He established that bacteria are distinct species.
Koch’s Postulates
The suspected causative agent must be found in every case of the disease and absent from healthy hosts.
The agent must be isolated and grown outside the host.
When introduced into a healthy, susceptible host, the agent must cause the disease.
The same agent must be found in the diseased experimental host.
Other Notable Scientists and Discoveries
Scientist | Year | Disease | Agent |
|---|---|---|---|
Albert Neisser | 1879 | Gonorrhea | Neisseria gonorrhoeae (bacterium) |
Carl Eberth | 1880 | Typhoid fever | Salmonella enterica serotype Typhi (bacterium) |
Robert Koch | 1882 | Tuberculosis | Mycobacterium tuberculosis (bacterium) |
Shibasaburo Kitasato | 1894 | Bubonic plague | Yersinia pestis (bacterium) |
Friedrich Loeffler and Paul Frosch | 1898 | Foot-and-mouth disease | Foot-and-mouth disease virus |
Robert Forde and Joseph Dutton | 1902 | African sleeping sickness | Trypanosoma brucei gambiense (protozoan) |

Gram Staining
Gram staining is a differential staining technique that distinguishes between Gram-positive and Gram-negative bacteria based on cell wall structure.

Prevention of Infection and Disease
Semmelweis: Advocated handwashing to reduce puerperal fever.
Lister: Developed antiseptic techniques using phenol.
Nightingale: Advanced nursing and hygiene practices.
Snow: Pioneered infection control and epidemiology (cholera outbreak in London).
Jenner: Developed the first vaccine (smallpox), founding immunology.
Ehrlich: Searched for "magic bullets" (chemotherapy).

Scientific Disciplines and Applications
Microbiology has given rise to numerous scientific disciplines, including industrial microbiology, immunology, virology, environmental microbiology, and pharmaceutical microbiology.

The Modern Age of Microbiology
Biochemistry and Metabolism
Biochemistry, the study of metabolism, began with Pasteur’s and Buchner’s work. Microbes serve as model systems for understanding biochemical reactions, which are shared by all living things. Applications include drug design, diagnosis, and treatment of metabolic diseases.
Microbial Genetics and Molecular Biology
Microbial genetics: Study of gene structure, function, and regulation in microorganisms.
Molecular biology: Explains cell function at the molecular level, including evolutionary relationships and taxonomy.
Recombinant DNA technology: Manipulation of genes for practical applications, such as producing human proteins in bacteria.
Gene therapy: Inserting or repairing genes in humans to treat disease.
Environmental Microbiology
Microorganisms play crucial roles in the environment, including bioremediation (detoxifying pollutants) and recycling elements like carbon, nitrogen, and sulfur.
Defending Against Disease
Serology: Study of blood serum and immune responses.
Immunology: Study of the body’s defense mechanisms against pathogens.
Chemotherapy: Use of chemicals to treat infectious diseases (e.g., penicillin, sulfa drugs).
The Future of Microbiology
Microbiology continues to evolve as new questions arise from ongoing research, driving the development of new scientific disciplines and medical advances.